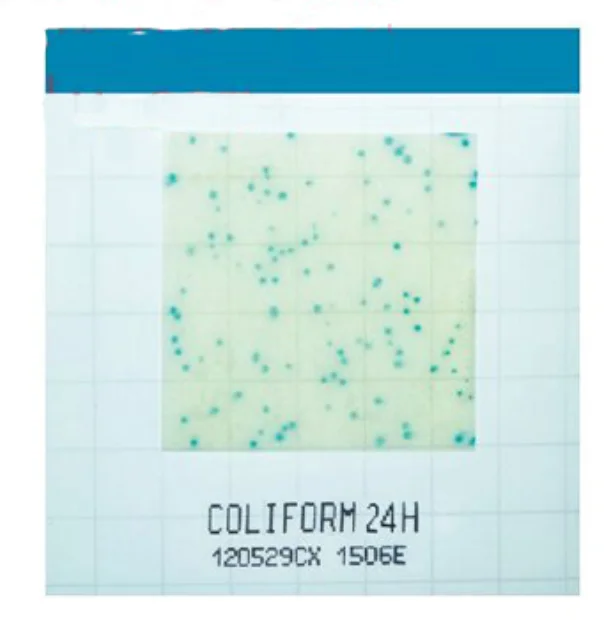

Quick Details Port: Shanghai, China Payment Terms: L/C,T/T,Western Union,Paypal Supply Ability: 100000 Kilogram/Kilograms per Year B4C Abrasive Grain Sizes: 50nm Usage: refractory materials Purity: 99% Appearance: black powder Place of origial: Shanghai, China Packaging Detail: B4C packaging:vacuum packing, 1kg/bag, 25kg/barrel, or as your request. Product Description Specification of B4C B4C MF: B4C B4C CAS No: 12069-32-8 B4C EINECS No: 235-111-5 B4C Appearance: Grey black powder B4C Particle size: Can be customized according to your requirements. Performance of B4C: 1 B4C possesses high purity, small particle size distribution, high specific surface area; 2 B4C is a synthetic ultra rigid materials, the hardness is 9.46; 3 56-6200Kg/mm2 microhardness, proportion was 252 g/cm3, melting is 2,250 degrees Celsius. Specifications for B4C: MF Particle Size Purity SSA Color Bulk Density B4C 50 nm >99% 42m2/g White 0.1g /cm3 Other size available of B4C: 500nm, 1um, 3um, 12.8um, 53um, 75um, 180um, etc. Packing Terms We supply different volume […]